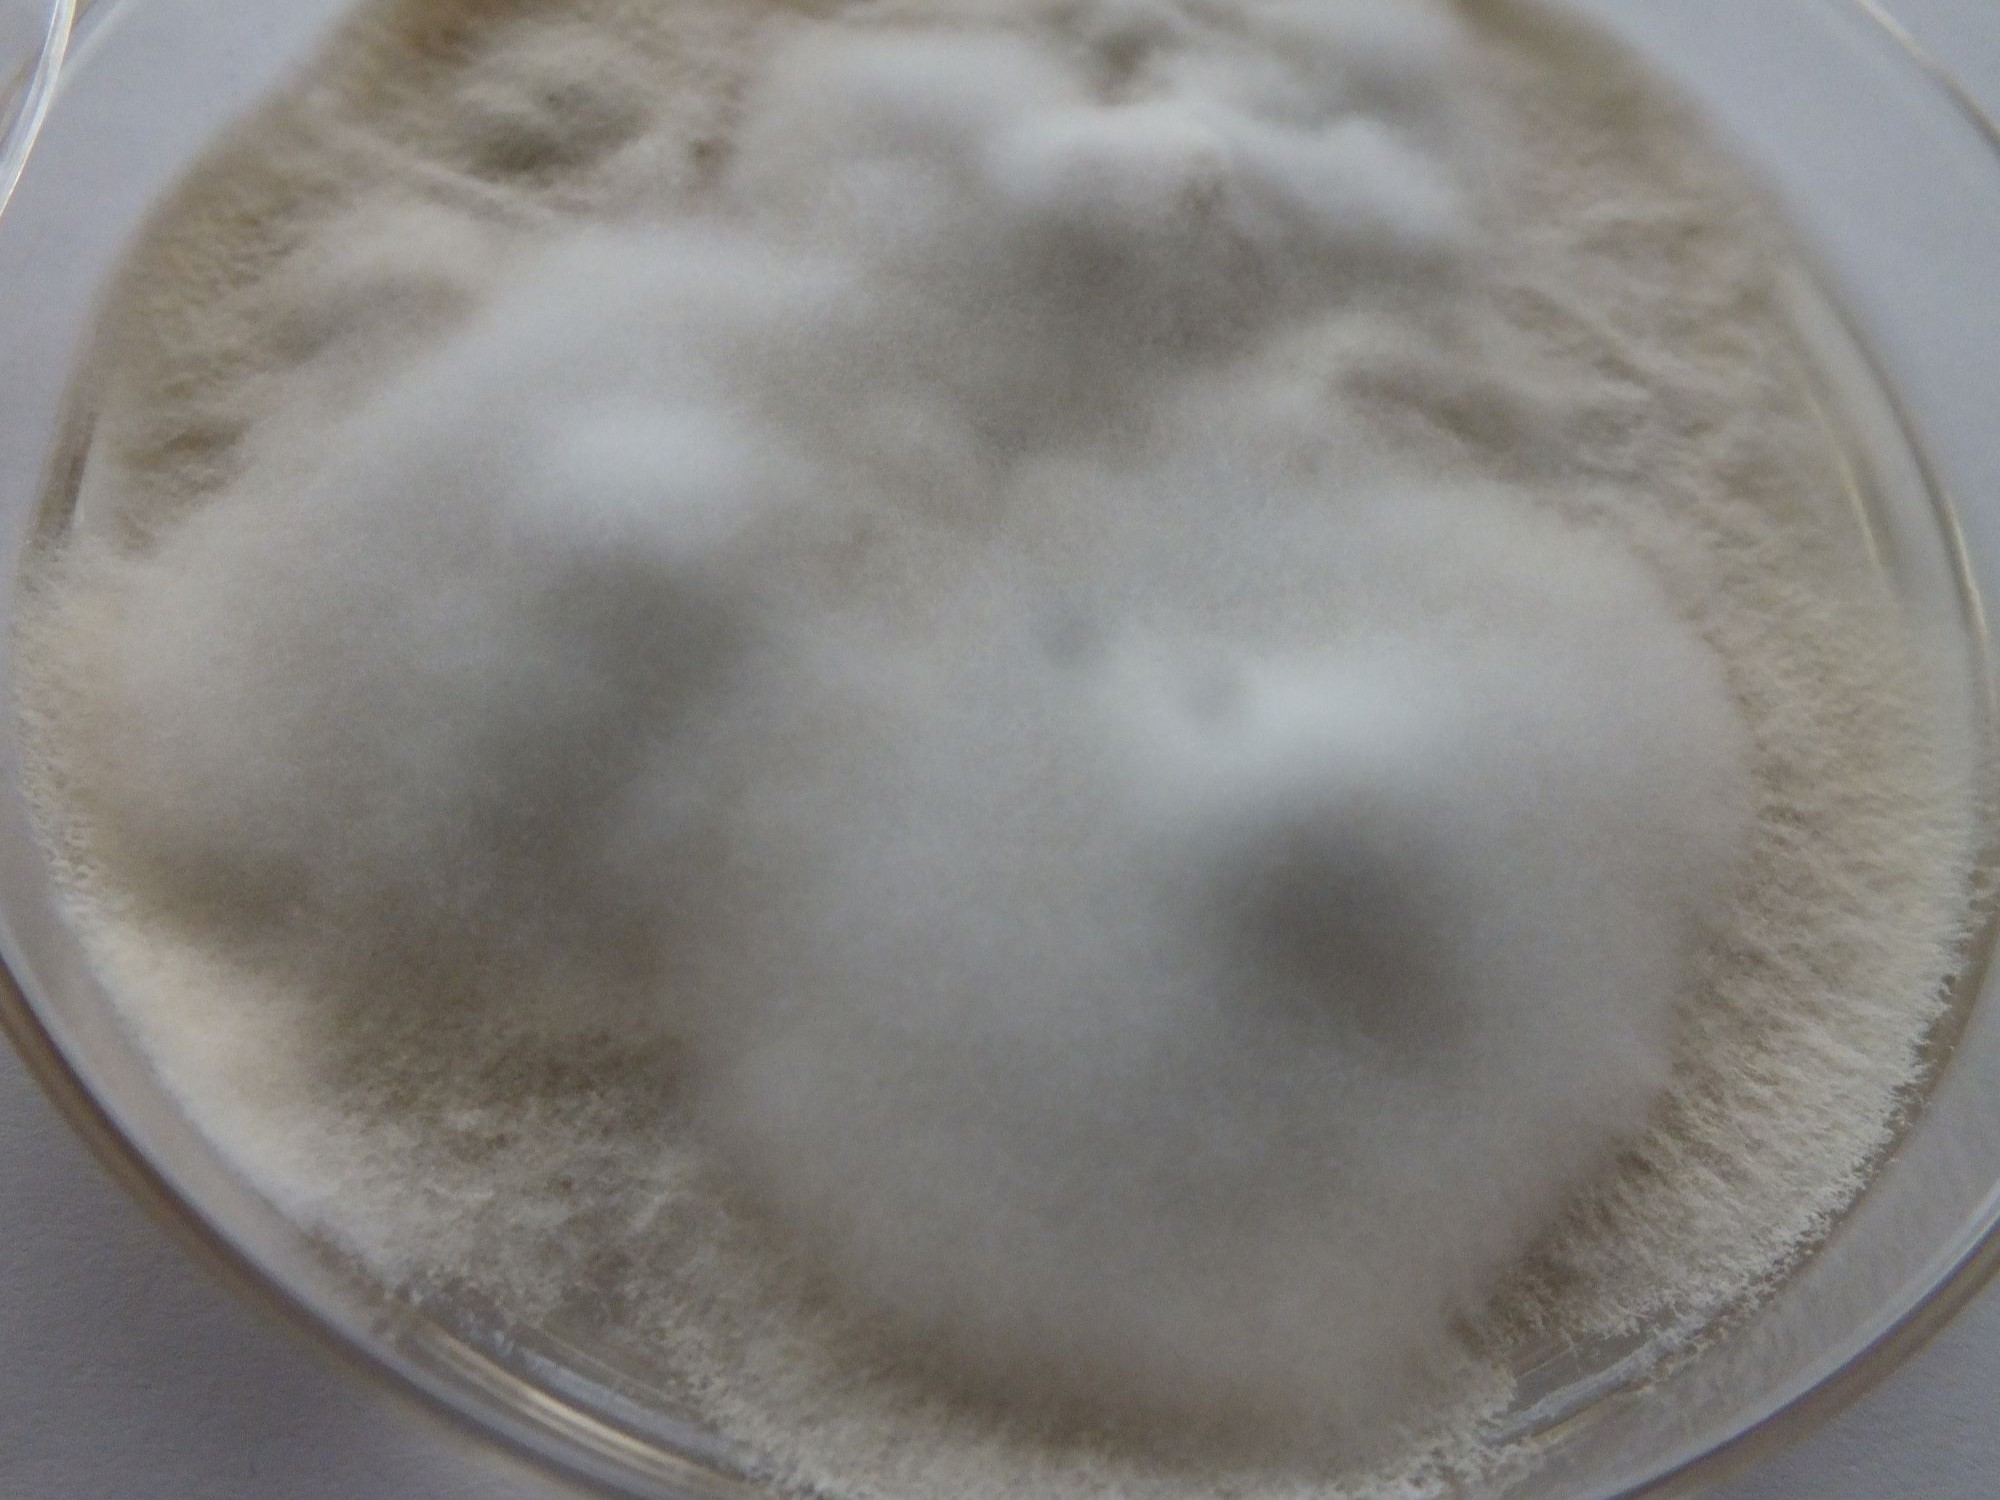
LABOPART Arthroderma tuberculatum

Aleuroplatus tuberculatus es un hemíptero de la familia Aleyrodidae, con una subfamilia: Aleyrodinae.
Fue descrita científicamente por primera vez por Takahashi en 1951.[1]
Referencias





Aleuroplatus tuberculatus es un hemíptero de la familia Aleyrodidae, con una subfamilia: Aleyrodinae.
Fue descrita científicamente por primera vez por Takahashi en 1951.[1]